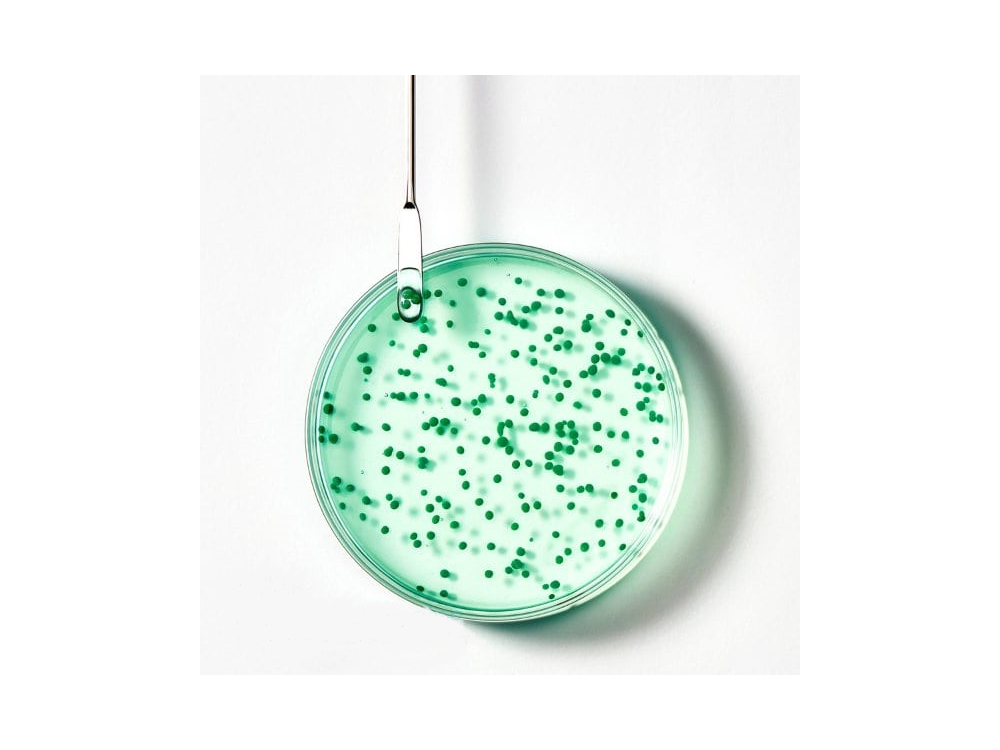
Rene Furterer Forticea Σαμπουάν Ενδυνάμωσης με Αιθέρια Έλαια, 600ml

Rene Furterer Forticea Σαμπουάν Ενδυνάμωσης με Αιθέρια Έλαια, 600ml
Σαμπουάν Ενδυνάμωσης με Αιθέρια Έλαια
Το σαμπουάν Forticea είναι σχεδιασμένο για κάθε τύπο μαλλιών. Συνδυάζει το Guarana, ένα ισχυρό φυσικό τονωτικό, με τις βιταμίνες Β5 και Β3 ή νιασιναμίδη και τις πολύτιμες δυνάμεις των βιοσφαιριδίων που περιέχουν ένα κοκτέιλ από τονωτικά αιθέρια έλαια, για να ξυπνήσουν τη δύναμη των μαλλιών. Από τη ρίζα, η συνεισφορά σε βιταμίνες και τονωτικά στοιχεία εντείνεται για μια ισχυρότερη, πιο ανθεκτική και πιο όμορφη ίνα.
Τα μαλλιά ενισχύονται, είναι υγιή και ζωντανεύουν με ενέργεια σε καθημερινή βάση. Ανάλαφρα και εύκολα στο styling, τα μαλλιά αποκτούν ισχυρό κράτημα.
97% φυσικά συστατικά. Χωρίς σιλικόνη, χωρίς θειικά επιφανειοδραστικά. Βιοδιασπώμενη σύνθεση*.
*Σύμφωνα με την οδηγία 301B του ΟΟΣΑ.
ΟΦΕΛΗ & ΠΛΕΟΝΕΚΤΗΜΑΤΑ
• 97% φυσικά συστατικά. Χωρίς σιλικόνη. Χωρίς θειικά επιφανειοδραστικά.
• ΚΑΘΑΡΙΖΕΙ ΑΠΑΛΑ: χάρη στη σύνθεσή του με 97% φυσικά συστατικά και χωρίς θειούχα επιφανειοδραστικά, αυτό το σαμπουάν καθαρίζει απαλά το τριχωτό της κεφαλής και δυναμώνει τα μαλλιά από τις ρίζες.
• ΔΥΝΑΜΩΝΕΙ ΚΑΙ ΑΝΑΖΩΟΓΟΝΕΙ: εμπλουτισμένο με εκχύλισμα Guarana, ένα φυσικό ενεργοποιητικό, καθώς και βιταμίνες και αιθέρια έλαια, βοηθά τα μαλλιά να ανακτήσουν τη δύναμη και τη ζωτικότητά τους. Γεμάτα ενέργεια, τα μαλλιά είναι ελαφρότερα διευκολύνοντας το styling.
• ΑΙΣΘΗΤΗΡΙΑΚΉ ΣΥΝΘΕΣΗ: η διάφανη και αστραφτερή υφή τζελ, γεμάτη πολύτιμα βιοσφαιρίδια αιθέριων ελαίων, περιβάλλει τα μαλλιά με ένα φρέσκο και αναζωογονητικό άρωμα με νότες εσπεριδοειδών και θυμαριού.
Οδηγίες Χρήσης:
• Συχνή χρήση
• Γαλακτωματοποιήστε σε βρεγμένο τριχωτό και κάντε απαλό μασάζ με κυκλικές κινήσεις. Αφήστε το να δράσει για 1 έως 3 λεπτά. Ξεπλύνετε.
Βάρος: 0.80 kg
Περιγραφή
Σαμπουάν Ενδυνάμωσης με Αιθέρια Έλαια
Το σαμπουάν Forticea είναι σχεδιασμένο για κάθε τύπο μαλλιών. Συνδυάζει το Guarana, ένα ισχυρό φυσικό τονωτικό, με τις βιταμίνες Β5 και Β3 ή νιασιναμίδη και τις πολύτιμες δυνάμεις των βιοσφαιριδίων που περιέχουν ένα κοκτέιλ από τονωτικά αιθέρια έλαια, για να ξυπνήσουν τη δύναμη των μαλλιών. Από τη ρίζα, η συνεισφορά σε βιταμίνες και τονωτικά στοιχεία εντείνεται για μια ισχυρότερη, πιο ανθεκτική και πιο όμορφη ίνα.
Τα μαλλιά ενισχύονται, είναι υγιή και ζωντανεύουν με ενέργεια σε καθημερινή βάση. Ανάλαφρα και εύκολα στο styling, τα μαλλιά αποκτούν ισχυρό κράτημα.
97% φυσικά συστατικά. Χωρίς σιλικόνη, χωρίς θειικά επιφανειοδραστικά. Βιοδιασπώμενη σύνθεση*.
*Σύμφωνα με την οδηγία 301B του ΟΟΣΑ.
ΟΦΕΛΗ & ΠΛΕΟΝΕΚΤΗΜΑΤΑ
• 97% φυσικά συστατικά. Χωρίς σιλικόνη. Χωρίς θειικά επιφανειοδραστικά.
• ΚΑΘΑΡΙΖΕΙ ΑΠΑΛΑ: χάρη στη σύνθεσή του με 97% φυσικά συστατικά και χωρίς θειούχα επιφανειοδραστικά, αυτό το σαμπουάν καθαρίζει απαλά το τριχωτό της κεφαλής και δυναμώνει τα μαλλιά από τις ρίζες.
• ΔΥΝΑΜΩΝΕΙ ΚΑΙ ΑΝΑΖΩΟΓΟΝΕΙ: εμπλουτισμένο με εκχύλισμα Guarana, ένα φυσικό ενεργοποιητικό, καθώς και βιταμίνες και αιθέρια έλαια, βοηθά τα μαλλιά να ανακτήσουν τη δύναμη και τη ζωτικότητά τους. Γεμάτα ενέργεια, τα μαλλιά είναι ελαφρότερα διευκολύνοντας το styling.
• ΑΙΣΘΗΤΗΡΙΑΚΉ ΣΥΝΘΕΣΗ: η διάφανη και αστραφτερή υφή τζελ, γεμάτη πολύτιμα βιοσφαιρίδια αιθέριων ελαίων, περιβάλλει τα μαλλιά με ένα φρέσκο και αναζωογονητικό άρωμα με νότες εσπεριδοειδών και θυμαριού.
Οδηγίες Χρήσης:
• Συχνή χρήση
• Γαλακτωματοποιήστε σε βρεγμένο τριχωτό και κάντε απαλό μασάζ με κυκλικές κινήσεις. Αφήστε το να δράσει για 1 έως 3 λεπτά. Ξεπλύνετε.